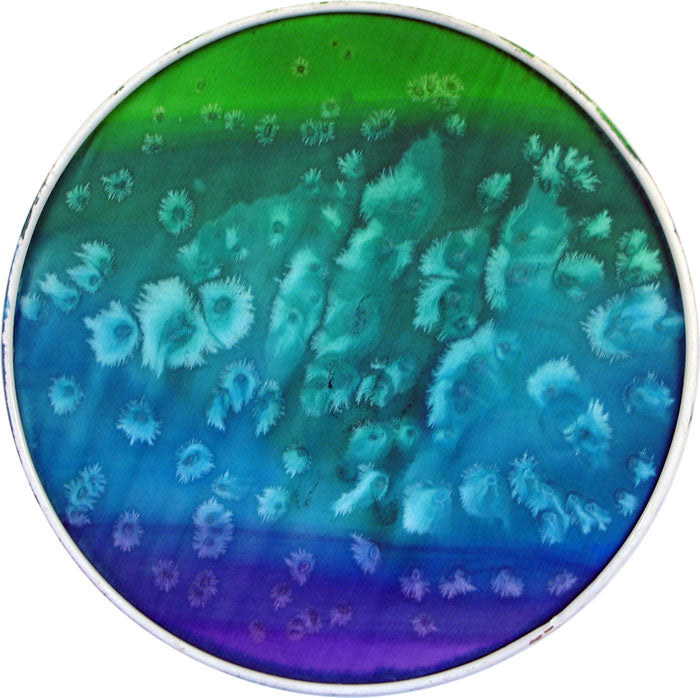

Hoop! There it is.
We finally got our hands on a silk hoop source! These hoops combine elegance and whimsy, making it the perfect addition to your decor or crafting projects. They make for luminous stained glass like ornaments and mobiles, especially when hung where light will shine through it. The best part is if you don't expose them to water, you can use any dye or silk paint on them without fixing them. Just remember silk paints like Dye-Na-Flow and Setasilk will fade much slower than dyes if hung in windows.
We also find that the dupont gutta works great on these. Worried about spreading and bleeding? Try our Dupont Anti-Fusant
Here's a rundown of what makes this hoop so special:
Size Matters: 8.25 inches in diameter, it's just the right size to make a statement without overwhelming your space.
Habotai Heaven: Made from 8mm habotai silk, known for its smooth texture and lightweight feel, it's like having a cloud stretched on a frame. It's giving baller on a budget vibes.
Sturdy and Stylish: The silk is meticulously stretched over a durable metal wire, ensuring it stays taut and in place.
Polyester Power: Wrapped with a layer of polyester thread, it adds an extra touch of durability, making it as tough as it is beautiful.